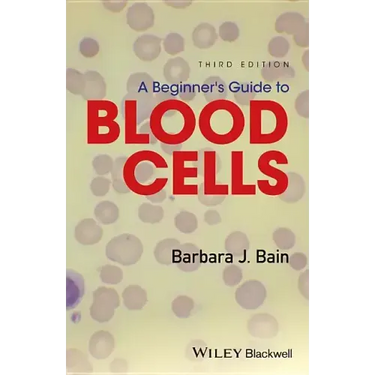
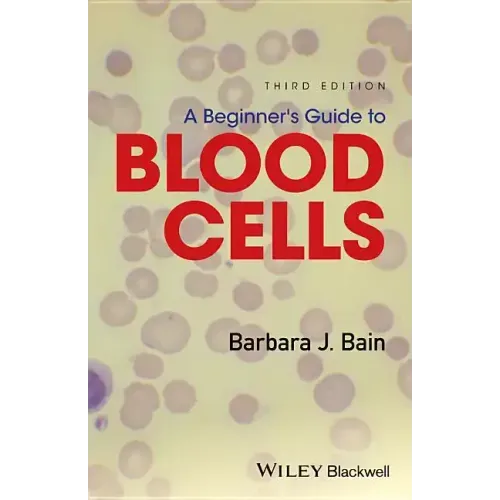

A Beginner's Guide to Blood Cells - Paperback
A Beginner's Guide to Blood Cells - Paperback
$93.33
/

Your payment information is processed securely. We do not store credit card details nor have access to your credit card information.
by Barbara J. Bain (Author)
The third edition of this popular pocket book, A Beginner's Guide to Blood Cells written by Professor Barbara Bain, provides a concise introduction to normal and abnormal blood cells and blood counts for trainees in haematology.
- Includes a brand new chapter on emergency morphology, designed to make the clinical significance and urgency of certain laboratory findings clear for biomedical scientists and to assist trainee haematologists in the recognition of major clinically important abnormalities
- Contains exceptional full colour images throughout
- Introduces important basic concepts of hematology, setting haematological findings in a clinical context
- Provides a fully updated self-assessment section
- An essential resource for trainee haematologists, biomedical scientists, and biomedical science and medical students
Back Jacket
The third edition of this popular pocket book, A Beginner's Guide to Blood Cells, written by Professor Barbara Bain, provides a concise introduction to normal and abnormal blood cells and blood counts for trainees in haematology. Now updated and expanded to include a brand new chapter on emergency morphology - designed to make the clinical significance and urgency of certain laboratory findings clear for biomedical scientists and to assist in the recognition of the major, clinically significant abnormalities all trainee haematologists must be familiar with before they go on call for laboratory haematology. This book:
- Contains exceptional full colour images throughout
- Introduces important basic concepts of haematology, setting haematological findings in a clinical context
- Provides a fully updated self-assessment section in the final chapter
- Offers an essential resource for trainee haematologists, biomedical scientists, and biomedical science and medical students
Author Biography
PROFESSOR BARBARA BAIN, MB BS, FRACP, FRCPath, Professor of Diagnostic Haematology, St Mary's Hospital Campus, Imperial College Faculty of Medicine, Consultant Haematologist, St Mary's Hospital, London, UK